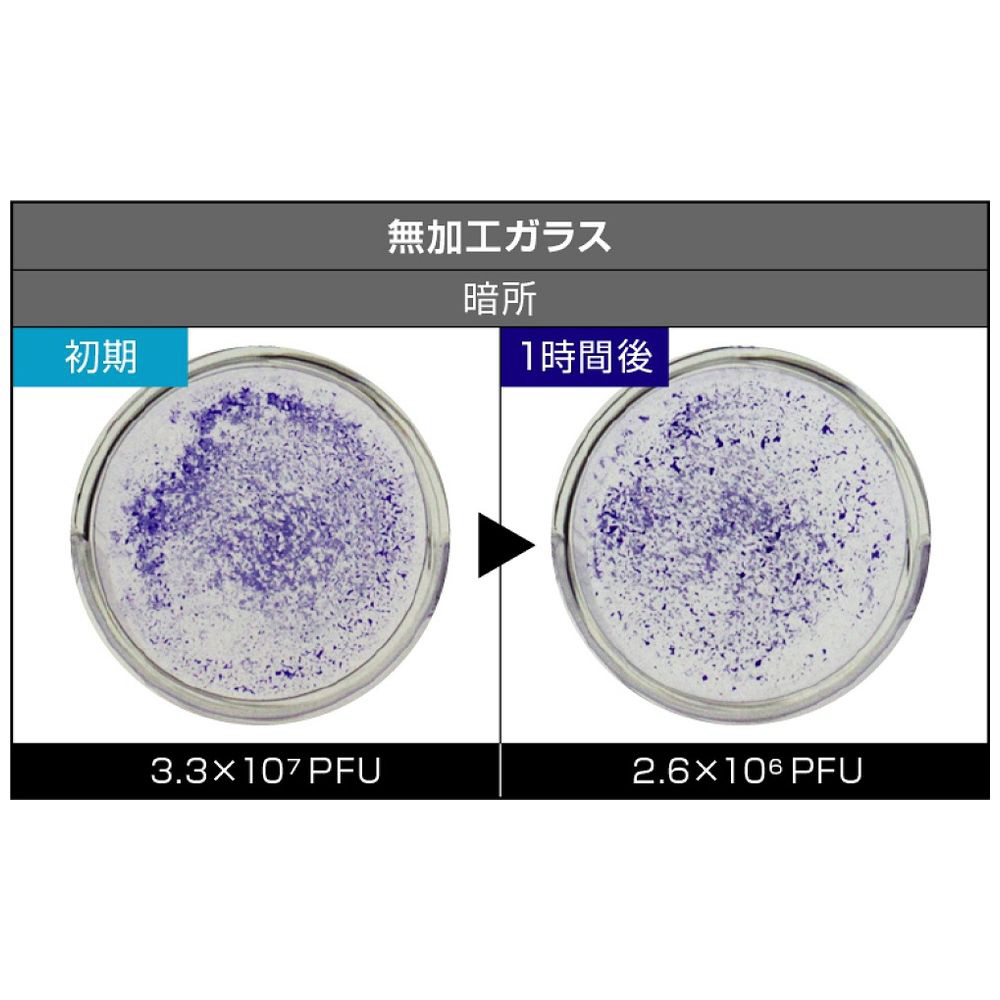

フジコー
Blue Deo S ブルーデオ S型 MC-S201 [適用畳数:8畳]
コンパクトでありながら、パワフル。
空気清浄機は【光】の時代へ
| ソフマップ特価 | ¥25,795(税込)消費税¥2,345税抜¥23,450 |
|---|---|
| 発売日 | 2023/07/01発売 |
| 在庫 |
在庫あり
通常24時間以内に出荷 お一人様10点まで |
| 送料 |
¥0(税込)
送料グループ:通常商品
|
| お支払い方法 |
ご利用いただけるPay払い |